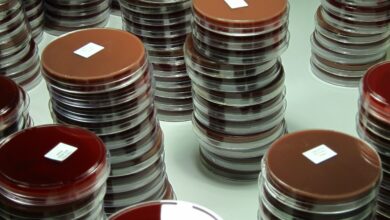

2025 Southern New England Heart Ball spojuje místní společnosti, aby vytvořily svět delších a zdravějších životů

Každoroční akce American Heart Association zvyšuje naději tím, že generuje finanční prostředky a povědomí o boji proti srdečním chorobám a mrtvici
PROZŘETELNOST, RI, 302025 — Srdeční onemocnění zbytky hlavní příčinou úmrtí v USA(1) Kromě toho, stárnutí, více pestrý Očekává se, že populace spolu s významným nárůstem rizikových faktorů srdečních chorob a mrtvice u mladších lidí do roku 2050 téměř ztrojnásobí celostátní cenu kardiovaskulárních chorob (CVD). nově zveřejněné projekce z American Heart Association.
Na Oct. 24, 2025 Jižní Nová Anglie Heart Ball spojil komunitní vůdce, dobrovolníky a přeživší, kteří pracují na změně této statistiky. The gala předvedeno jak výzkum, objev, advokacie a znalosti, které mají vliv, mohou změnit výsledky v oblasti zdraví všech, všude v Jižní Nová Anglie. Čím více než 415 000 dolarů raised pomůže podpořit život zachraňující práci Americké kardiologické asociace, která již více než 100 let podporuje zdraví a naději pro každého a všude.
„Jsme poctěni a nadšeni, že společnost DiSanto, Priest & Co. mohla pomoci v čele Heart Ball, který vybral 415 000 dolarů – důkaz neuvěřitelné štědrosti a odhodlání naší komunity něco změnit,“ řekl Mike Mellor, partner společnosti DiSanto, Priest & Co. důležité příčiny. jsme vděčný každému, kdo účastnili a přispěl k tomuto úspěchu, který bude přímo dopad žije v naší komunitě.“
Akce byla završením celoročního Heart of Jižní Nová Anglie kampaň, která se snaží spravedlivě zlepšit a zachránit životy před srdečními chorobami a mrtvicí. The Jižní Nová Anglie Heart Ball představuje okamžik v čase, kdy je třeba reflektovat, ctít a oslavovat pokrok dosažený objevem převratného výzkumu, pokroků v spravedlivý zdraví, úsilí o obhajobu na místní úrovni, stát a federálních úrovních a vybavování komunit znalostmi zachraňujícími život.
Priest & Co, sloužil jako židle na letošní akci konanou v hod v hotelu Omni v Providence kterou moderovala Lindsay Iadeluca a více než 300 místní hosté zúčastnil. Během celé akce se sedm místních dobrovolníků podělilo o své příběhy o přežití, o život zachraňující advokacii a dopad na komunitu přivést poslání k životu Jižní Nová Anglie.
„Jsme hluboce vděční našim hostům, sponzorům a dobrovolníkům za to, že letošní ročník byl obrovským úspěchem,“ řekl Michelle Clark, výkonná ředitelka American Heart „Jejich štědrost a podpora jsou zásadní pro poslání Americké kardiologické asociace v boji proti srdečním chorobám a mrtvici. Budoucnost asociace je o zlepšení té vaší. Zveme celou komunitu ke spolupráci, abychom mohli zlepšit zdraví a naději pro všechny v Jižní Nová Anglie.“
American Heart Association je přední světová nezisková organizace, která se zaměřuje na zdraví srdce a mozku. Pro více informací o tom, jak podpořit Americkou srdeční asociaci navštivte 2025-2026 Srdcový ples jižní Nové Anglie . Chcete-li se zapojit, kontaktujte prosím Lindsay.Iadeluca@heart.org.
O American Heart Association
American Heart Association je neúprosnou silou pro svět delších a zdravějších životů. Věnováno zajištění spravedlivý zdraví ve všech komunitách, organizace je předním zdrojem informací o zdraví již více než sto let. S podporou více než 35 milionů dobrovolníků po celém světě financujeme převratný výzkum, obhajujeme veřejné zdraví a poskytujeme kritické zdroje pro záchranu a zlepšení životů postižených kardiovaskulárními chorobami a mrtvicí. Díky průlomům a implementaci osvědčených řešení ve vědě, politice a péči neúnavně pracujeme na tom, abychom zlepšovali zdraví a proměňovali životy každý den. Spojte se s námi heart.orgna Facebooku, X nebo na čísle 1-800-AHA-USA1.
Pro dotazy médií: 214-706-1173
Kontakt: 401-864-8627; samantha.bowen@heart.org
Pro veřejné dotazy: 1-800-AHA-USA1 (242-8721)